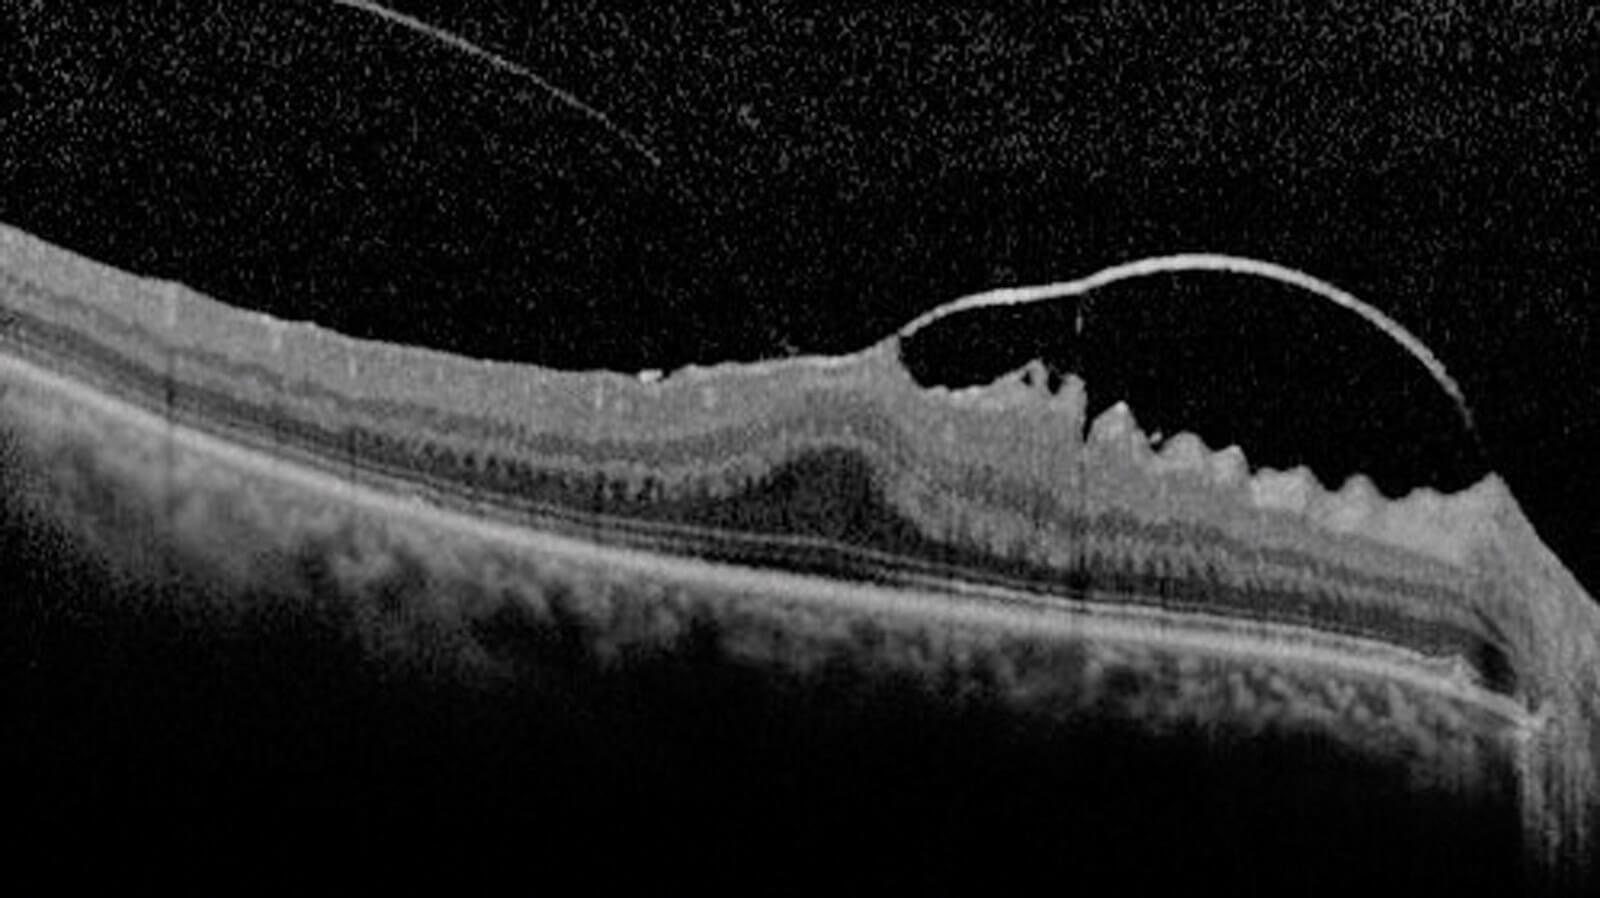
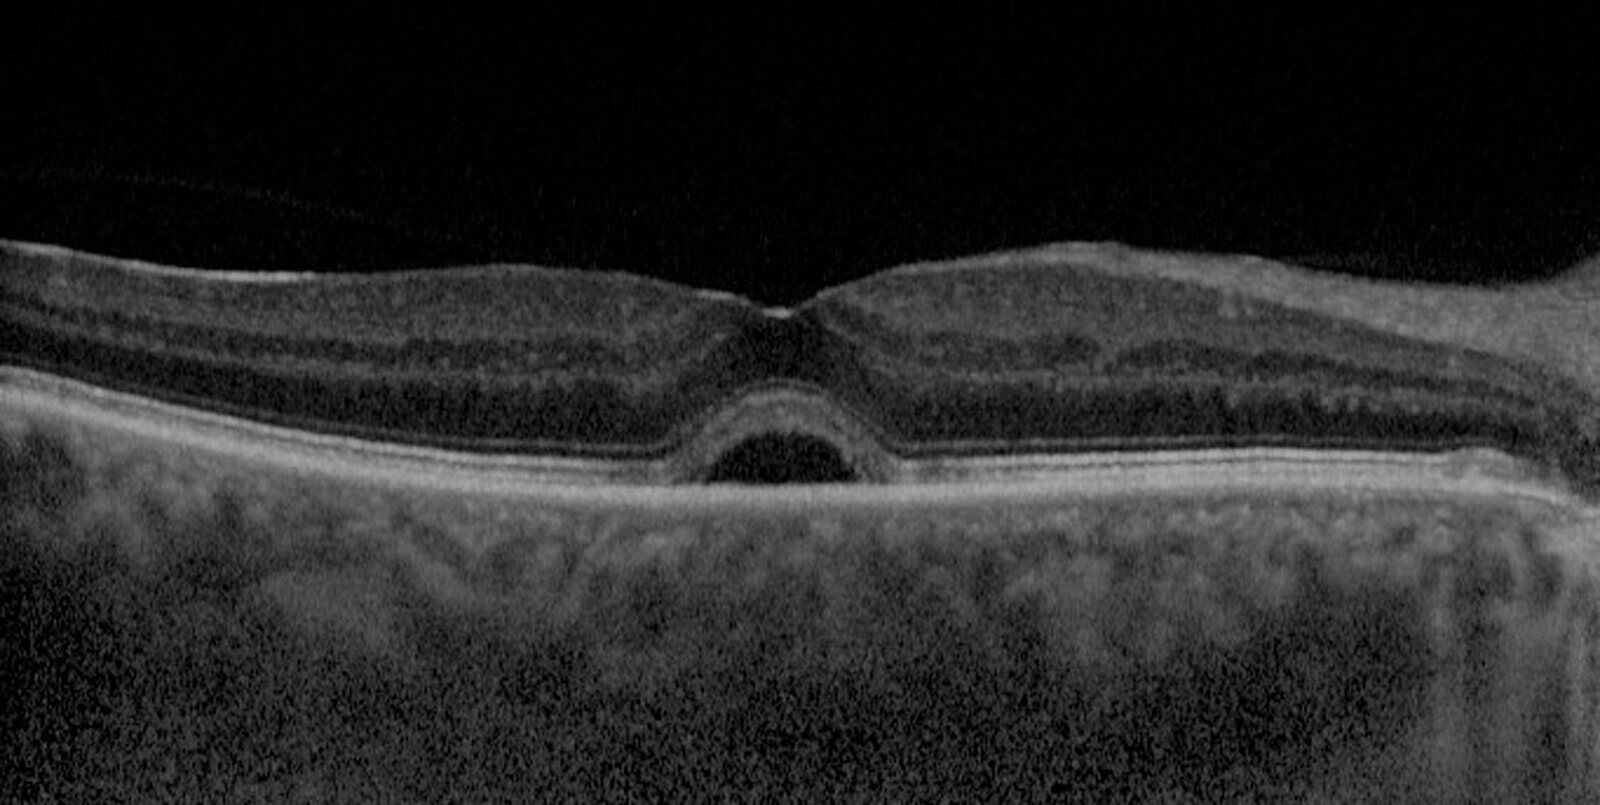
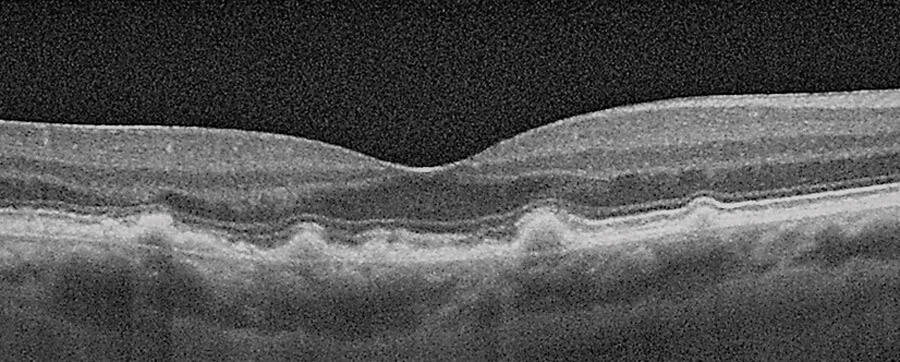

The evolution of ophthalmic imaging technologies has been particularly rapid over the last few years. The author provides an update of the current terms for common signs and pathologies observed using optical coherence tomography.
My experience as an ophthalmic technician, as an ophthalmic photographer and later as a specialist in retinal photography and clinical education, has helped me to understand that the basis for sharing experiences and knowledge are fundamental in the scientific community.
The purpose of this article is to propose a reminder of the most updated nomenclature and classification relating to the most common signs and pathologies that can be observed in daily clinical activity and increasingly with non-invasive imaging techniques such as optical coherence tomography (OCT).
Figure 1: SD-OCT scan of focal VMA+VMT+ ERM.

Figure 2: SD-OCT Scan of PH+ERM.
Nomenclature and classification through optical coherence tomography
Vitreo-macular adhesion (VMA): It can be described as focal or broad. It is the condition in which the vitreous adheres to the retina in a strongly anomalous way. As for the VMA, it is to be considered:
- Focal VMA with and X≤1500 microns
- Broad VMA with an X>1500 microns.
Vitreo-macular traction (VMT): This syndrome is characterised by an incomplete detachment of the vitreous (PVD). Vitreo-macular traction can be classified from the morphological point of view (as J-shaped and V-shaped) and from the point of view of the diameter (as focal or broad). From the point of view of the dimension, as for the previously mentioned VMA, we can have:
- Focal VMT with an X≤1500 microns.
- Broad VMT with an X>1500 microns.
Furthermore, VMA and VMT can present on OCT scans as either isolated (single sign) or concomitant (with other signs).
Epiretinal membrane (ERM): It is a fibro-cellular, avascular and semitranslucent membrane. This sign can be classified as:
- Idiopathic, with unidentifiable aetiology.
- Primary, caused by vitreous detachment.
- Secondary caused by another aetiology.
Macular hole (MH): The new classification is based on the morphology of this retinal defect, typically present in the macular area and can thus be classified with three factors.
- Factor 1 (Dimension): small, medium, large. This measurement, i.e. by size, is made horizontally through the hole at the narrowest point and is thus classified:
- Small: X≤ 250 microns
- Medium: X>250 microns and ≤ 400 microns
- Large: X> 400 microns - Factor 2 (Cause):
- Primary, i.e. initiated by vitreo-macular traction
- Secondary, i.e. due to a trauma or disease known to cause MH without the presence of prior VMT. - Factor 3: presence or absence of VMT.
Lamellar macular hole (LMH): It is characterised by an irregular foveal contour and is often associated with an epiretinal membrane; a further visible feature is a split between the outer plexiform layer and the outer nuclear layer.
Pseudo-macular hole (PH): There is no interruption of the retinal layers instead present in the macular hole. The similarity is given by the alteration of the foveal profile usually caused by an epiretinal membrane or by a traction syndrome.
Macular neovascularisation type 1 (MNV type 1): Formerly known as occult or CNV type 1. The neovascular complex develops from the choroid to the retinal pigment epithelium.
Macular neovascularisation type 2 (MNV type 2): Formerly known as classic or CNV type 2. The neovascular complex develops in the subretinal space up to the retinal pigment epithelium.
Macular neovascularisation type 3 (MNV type 3): Formerly known as retinal angiomatous proliferation or RAP. The neovascular complex develops downwards, also penetrating the retinal pigment epithelium.
Polypoidal choroidal vasculopathy (PCV): In retinal imaging with SD-OCT it is possible to observe a clear similarity with the previously mentioned MNV type 1; the observable pattern in the retinal pigmented epithelium (RPE) may show the presence of nodular areas.
Fibrosis: In OCT classification it can be described as a hyper-reflective material with multi-laminar shapes.
Intraretinal fluid: Spaces of cystoid type associated with retinal thickening. It was proposed as cystoid oedema in the previous nomenclature.
Subretinal fluid: Space of separation of the neurosensory retina from the RPE.
Lipid: Known as hard exudates, they are material present in the retina or subretinal area.
RPE and outer retinal atrophy: According to OCT classification and description, it is referred to as a complete reduction or loss of RPE. Previously referred to as geographic atrophy.
Outer retinal atrophy: Prior to OCT classification it was not classified. In OCT, it is described as the loss of the ellipsoid and interdigitation zone and with reduction of the outer nuclear layer.
Figure 3: SD-OCT scan of subretinal fluid.
Figure 4: OCT scan of Drusen.

Figure 5: TD-OCT vs. SD-OCT.
Subretinal hyper-reflective material: This term was born with the advent of classification by observation in OCT images. It is exudation material present in the sub-retinal area.
Outer retinal tubulation (ORT): Visible sign in OCT. ORT is a sign of photoreceptor degeneration and chronicisation of the degenerative pathology. It is identifiable as a rounded or ovoid structure with hyper-reflective edges.
Drusen and other deposits: Are a lipoprotein type extracellular deposit that is deposited under the RPE. They can be classified by their size as:
- Small (drupelets): X< 63 microns
- Intermediate: X≥ 63 microns and X ≤125 microns
- Large: X> 125 microns.
Differently we can find: subretinal drusenoid deposits (know as pseudo-drusen) traceable above the RPE and a further type of drusenoid deposit, called cuticular drusen, located between the basal lamina of the RPE and the inner collagenous layer of Bruch’s membrane.
Retinal pigment epithelium detachment (PED): Known as retinal PED, this is the detachment between the RPE and Bruch’s membrane, which usually appears as a single hyper-reflective layer in OCT scanning. This sign can be classified as:
- Serous
- Fibrovascular
- Drusenoid.

Evolution of technology
Those described above are the main signs and related updated nomenclature that can be detected in daily clinical activities related to retinal imaging using an OCT.
In the last 15 years, the evolution of technologies has been more rapid than before. When I started my clinical activity, I was working with time domain OCT; subsequently with the introduction of spectral domain OCT, the approach to the signs that could be observed changed thanks to the significantly improved image quality.
Subsequently, OCT angiography (OCTA) entered the market which, together with the concept of multimodal retinal imaging, made it possible to offer the patient earlier diagnoses thanks to more reproducible imaging.
The advantage of using OCT technology in updating classification and nomenclature is due to the diffusion of the instrumentation itself, its reproducibility and the possibility of repeating the examination to the patient several times and at any time, unlike retinal examinations with dye.
With these technologically innovative acquisition methods, which offer an already known reading basis, it was also possible to change, update and differentiate the nomenclature, previously based on retinography and on fluorangiographic and indocyaninographic images.
Sharing the most up-to-date nomenclature possible is essential in order to be able to discuss at various clinical levels and between different professional figures.
This update in the classification will continue over time, with the evolution of technologies and research results, as the scientific world is increasingly dynamic. However, it is correct to point out that even today the previous nomenclature is still used in parallel since for some signs it has remained unchanged.
To conclude, I invite all readers and professionals to keep the evolution of retinal imaging technologies and related nomenclature updated as much as possible.
Further reading
• Stevenson W, Prospero Ponce CM, Agarwal DA, et al. Epiretinal membrane: optical coherence tomography-based diagnosis and classification. Clin Ophthalmol 2016;10:527-34.
• Bottòs J, Elizalde J, Rodrigues EB, et al. Classifications of vitreomacular traction syndrome: diameter vs morphology. Eye (Lond) 2014;28(9):1107-12.
• Ersoz MG, Karacorlu M, Arf S. Retinal pigment epithelium tears: Classification, pathogenesis, predictors, and management. Surv Ophthalmol 2017;62(4):493-505.
• Goldberg NR, Greenberg JP, Laud K, et al. Outer retinal tubulation in degenerative retinal disorders. Retina 2013;33(9):1871-6.
• Spaide RF, Jaffe GJ, Sarraf D, et al. Consensus Nomenclature for Reporting Neovascular Age-Related Macular Degeneration Data: Consensus on Neovascular Age-Related Macular Degeneration Nomenclature Study Group. Ophthalmology 2020;127(5):616-36.
• Benyamini S, Loewstein A, Moisseiv E. Evaluation of accuracy and uniformity of the nomenclature of vitreoretinal interface disorders. Retina 2020;40(7):1272-8.
• Zweifel SA, Engelbert M, Laud K, et al. Outer retinal tubulation: a novel optical coherence tomography finding. Arch Ophthalmol 2009;127(12):1596-602.
• Spaide RF, Curcio CA. Drusen characterization with multimodal imaging. Retina 2010;30(09):1441-54.
Declaration of competing interests: The author was previously employed by Miloftalmica, Italy, which managed the Heidelberg Engineering and Imagine Eyes brands, and was responsible for the provision of education / training related to ophthalmic instrumentation.
COMMENTS ARE WELCOME



